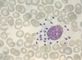

- Лейшманиозы
- (leishmanioses) — группа трансмиссивных протозойных болезней, вызываемых жгутиковыми простейшими рода Leishmania, переносчиками которых служат москиты, относящиеся к роду Phlebotomus
Висцеральный лейшманиоз (leishmaniosis visceralis) характеризуется хроническим течением, волнообразной лихорадкой, сплено- и гепатомегалией, кахексией, анемией и лейкопенией. Различают индийский (кала-азар, черная болезнь), средиземноморский и восточноафриканский висцеральный лейшманиоз.
Индийский висцеральный лейшманиоз распространен в Индии, Пакистане, Бангладеш, Непале, Китае. Возбудитель — Leishmania donovani (рис. 1). Источником возбудителя болезни является больной человек, переносчиком — москиты рода Phlebotomus, в кишечнике которых возбудитель проходит полный цикл развития в течение 6—8 сут. Заражение человека происходит при укусе москитом. Возможны спорадические случаи и периодически возникающие эпидемические вспышки. Из места укуса возбудитель проникает гематогенным путем в клетки системы мононуклеарных фагоцитов. Преимущественно поражаются селезенка, печень, костный мозг, лимфатические узлы, в которых возникают воспалительные, дистрофические и некротические изменения. При гибели лейшманий и в процессе их метаболизма образуются токсические вещества, обусловливающие общую интоксикацию и специфическую сенсибилизацию организма больного. После перенесенной болезни остается стойкий иммунитет.
Инкубационный период длится в среднем 6—8 мес. В начальном периоде болезни наблюдаются слабость, снижение аппетита, небольшое увеличение селезенки. Период разгара характеризуется длительной волнообразной лихорадкой с периодами ремиссий, выраженной спленомегалией, увеличением печени. Селезенка и печень плотные, безболезненные при пальпации. Кожный покров приобретает темный цвет, возникает полиаденит, прогрессирует похудание. Нарастают анемия и лейкопения вплоть до агранулоцитоза, нередки геморрагические проявления в виде кровоточивости слизистых оболочек, кровоизлияний в кожу и др. Появляются периферические отеки и асцит. У части больных на коже обнаруживаются узелковые или пятнистые высыпания — кожные лейшманоиды. В терминальной стадии болезни развивается кахексия.
Диагноз основывается на клинико-эпидемиологических данных и подтверждается обнаружением возбудителя в мазках и толстой капле крови, пунктатах костного мозга, биоптатах лимфатических узлов, селезенки, печени. Возможно выделение культуры возбудителя из биопсийного материала. Используются также серологические методы исследования. Дифференциальный диагноз проводят с малярией, бруцеллезом, хрониосепсисом, лейкозом, лимфогранулематозом. Лечение осуществляется в условиях стационара препаратами 5-валентной сурьмы, пентамидином.
Прогноз при несвоевременных диагностике и лечении неблагоприятный.
Средиземноморский висцеральный лейшманиоз регистрируется в странах Средиземноморья, на Ближнем Востоке, в Казахстане, Средней Азии и Закавказье. Возбудитель — L. donovani infantum. Источником возбудителя болезни в городах являются собаки, в сельской местности также шакалы и лисы, переносчиком — москиты рода Phlebotomus. Болеют в основном дети от 1 года до 5 лет. Заболеваемость носит преимущественно спорадический характер. Патогенез в основных чертах тот же, что и при индийском висцеральном Л. После перенесенной болезни остается стойкий иммунитет. Инкубационный период от 20 дней до 3—6 мес. На месте укуса в части случаев возникает первичный аффект в виде папулы. Клиническая картина отличается от индийского висцерального Л. отсутствием кожных лейшманоидов, бледностью кожи, возможным острым течением болезни. Диагноз, лечение и прогноз такие же, как при индийском висцеральном лейшманиозе.
Восточноафриканский висцеральный лейшманиоз регистрируется в Судане и Кении. Возбудитель — L. donovani archibaldi. Источник возбудителя инфекции — больной человек и млекопитающие из отряда грызунов и хищников, переносчик — москиты рода Phlebotomus. Заболеваемость преимущественно спорадическая, но возможны вспышки. К клиническим особенностям относятся: частое развитие первичного аффекта в виде папулы или язвы, нередко позднее появление кожных лейшманоидов, рецидивирующее течение болезни. Диагноз, лечение и прогноз такие же, как при индийском висцеральном лейшманиозе.
Профилактика висцерального Л. направлена на обезвреживание источника возбудителя, уничтожение переносчиков и защиту людей от заражения. В очагах висцерального Л., где источником возбудителей инфекции являются собаки, проводят обследование, учет и лечение последних, а также уничтожение больных бродячих собак. Для уничтожения москитов помещения обрабатывают инсектицидами (см. Дезинсекция). Для защиты людей от нападения москитов используют репелленты и механические средства (защитные сетки, засетчивание окон и дверей, пологи над постелью).
Кожный лейшманиоз (leishmaniosis cutanea) характеризуется ограниченными поражениями кожи с ее изъязвлением и последующим рубцеванием. По этиологии, географическому распространению различают антропонозный и зоонозный кожный лейшманиоз Старого Света и кожный лейшманиоз Нового Света.
Антропонозный кожный лейшманиоз Старого Света (синоним поздно изъязвляющийся кожный лейшманиоз) встречается в Южной Европе, на Ближнем Востоке, в Африке. Индии, Пакистане. Узбекистане и Туркмении. Возбудитель — L. tropica minor (рис. 2). Источник возбудителя инфекции — больной человек, переносчик — москиты рода Phlebotomus. Инфицированная самка через 6—8 дней становится заразной. Передача возбудителя инфекции происходит при укусе или раздавливании москита. Возбудитель размножается в месте внедрения. Общая реакция организма выражена слабо. После перенесенной болезни остается стойкий иммунитет.
Инкубационный период продолжается от 3 мес. до 11/2 года и более. Первоначально на коже образуется небольшая папула розового цвета с гладкой поверхностью, которая увеличивается, достигая через 3—6 мес. 1—2 см в диаметре, покрывается коркой. После отпадения корки образуется неглубокая язва с зернистым дном, покрытая гнойным налетом. Края язвы инфильтрированы, она постепенно увеличивается, достигая 4—6 см в диаметре. К 8—10-му месяцу болезни в центре и по периферии язвы появляются грануляции, а к концу 12-го месяца она полностью зарубцовывается. Язвы чаще локализуются на лице и верхних конечностях, количество их варьирует от 1—3 до 8—10.
Диагноз основывается на клинико-эпидемиологических данных и подтверждается бактериоскопией мазков, взятых с краев язв, выделением культуры возбудителя и с помощью биологической пробы на лабораторных животных. Дифференциальный диагноз проводят с сифилисом, лепрой, тропическими язвами. Лечение осуществляют мономицином и аминохинолином. Прогноз благоприятный.
Зоонозный кожный лейшманиоз Старого Света (синоним рано изъязвляющийся кожный лейшманиоз). Возбудитель — L. tropica major. Источник и резервуар возбудителя инфекции — грызуны, переносчик — москиты. Заражение человека происходит через москитный укус. После перенесенной болезни остается стойкий иммунитет. Инкубационный период от 1 нед. до 11/2 мес. В отличие от поздно изъязвляющегося кожного Л. очаг поражения кожи имеет большие размеры, больше выражена воспалительная инфильтрация, язва диаметром до 10—15 см и более образуется через 1—2 нед. от начала болезни. Вокруг первичного элемента нередко появляются множественные вторичные бугорки со склонностью к изъязвлению (рис. 3). Рубцевание язв начинается через 2—4 мес. и заканчивается в пределах 6—7 мес. Лейшманиомы локализуются чаще на нижних конечностях, реже на туловище и на лице. Диагноз, лечение и прогноз такие же, как при антропонозном кожном лейшманиозе.
Кожный лейшманиоз Нового Света вызывается L. mexicana (мексиканский кожный лейшманиоз), L. braziliensis (бразильский кожный лейшманиоз) и L. peniviana (перуанский кожный лейшманиоз). Встречается в Южной и Центральной Америке, источники инвазий — грызуны, многие дикие и домашние животные. Инкубационный период от 2—3 нед. до 1—3 мес. На месте укуса москита развиваются язвы, обычно глубокие, нередко в патологический процесс вовлекаются слизистые оболочки, часто наблюдаются лимфадениты и лимфангииты. Рубцовые изменения вызывают грубые деформации носа, ушных раковин, носоглотки, гортани, наружных половых органов. Возможны бактериально-септические осложнения. Течение длительное. Лечение проводят препаратами 5-валентной сурьмы. Прогноз неблагоприятный.
Профилактика кожного Л. состоит в раннем выявлении и лечении больных, истреблении грызунов в очагах зоонозного кожного Л., борьбе с москитами (как при висцеральном Л.), вакцинации живой культурой лейтманий ограниченных групп населения, например сезонных рабочих, новоселов, участников экспедиций перед выездом их в районы, эндемичные по зоонозному кожному Л. (не позднее чем за 3 мес.).
См. также Трансмиссивные болезни.
Библиогр.: Лейшмании, под ред. В.М. Сафьянова и др., Л., 1982; Руководство по зоонозам, под ред. В.И. Покровского, с. 242, Л., 1983; Руководство по тропическим болезням, под ред. А.Я. Лысенко, с. 131, М., 1983.